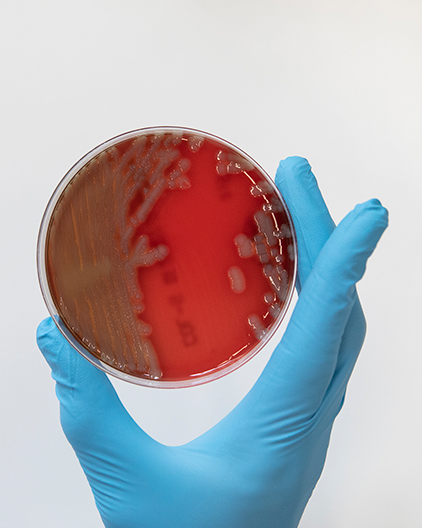

Les directives sur les doses d’antibiotiques dans l'alimentation pourraient sous-estimer le risque de résistance

Selon une étude menée par l'IMT d'Anvers, même des concentrations infimes d'antibiotiques dans la viande et le poisson que nous mangeons peuvent contribuer à la résistance aux antibiotiques.. Les chercheurs ont mené des expériences sur des larves de fausse teigne et ont découvert que même une dixième de la quantité " sécuritaire " d'antibiotiques peut induire une résistance, rendant les infections impossibles à traiter. Ils étendent actuellement leurs recherches aux souris et aux humains.
Une étude précédente de l'IMT avait découvert des bactéries résistantes aux antibiotiques dans la bouche de Belges qui n'avaient pas utilisé d'antibiotiques depuis des décennies. On s'inquiété du fait que même de petites quantités d'antibiotiques dans les aliments peuvent entraîner une résistance. Cette situation est particulièrement alarmante pour les bactéries telles que Klebsiella pneumoniae, qui sont connues pour causer des infections graves comme la pneumonie, et qui deviennent de plus en plus résistantes aux traitements.
Des organisations internationales telles que l'Agence européenne des médicaments (EMA), l'Organisation mondiale de la Santé (OMS) et l'Organisation des Nations Unies pour l'alimentation et l'agriculture (FAO) ont fixé une limite à la quantité d'antibiotiques dans les aliments. Cette limite vise à empêcher les antibiotiques de tuer les bactéries bénéfiques présentes dans notre corps. Une nouvelle étude menée par l'IMT montre que même des concentrations mille fois inférieures à cette limite peuvent entraîner une résistance aux antibiotiques.

Petites larves, gros problème
Pour comprendre l'influence des antibiotiques sur la résistance, les chercheurs ont utilisé des larves de fausse teigne. Ces larves sont souvent utilisées pour étudier les infections bactériennes car leurs réactions ressemblent beaucoup à celles des humains. Les scientifiques testent généralement les substances d'abord sur les teignes, puis sur les souris et enfin sur les humains. Cette approche progressive permet de combler le fossé entre les expériences de laboratoire et les applications dans le monde réel, car les organismes vivants peuvent réagir différemment des boîtes de laboratoire ou des tubes à essai.
De manière surprenante, les expériences ont montré que même une dixième de la quantité "sûre" de ciprofloxacine qui est un antibiotique couramment utilisé chez les porcs et les vaches pourrait favoriser la résistance des bactéries dans les larves, ce qui rend les infections impossibles à traiter.
Les bactéries dont se nourrissent les larves de la fausse teigne sont non seulement courantes chez l'homme et les animaux, mais elles sont également à l'origine de nombreuses infections graves. Fait alarmant, ces bactéries font partie du groupe le plus susceptible de développer une résistance aux traitements. En outre, les chercheurs ont découvert qu'une seule dose de l'antibiotique érythromycine dans l'alimentation, soit la quantité quotidienne "acceptable", peut entraîner une résistance chez la bactérie Streptococcus pneumoniae, responsable de la pneumonie.
Implications pour la santé publique
Nous cherchons actuellement à comprendre si des doses "acceptables" d'antibiotiques provoquent une résistance similaire chez les souris et les humains", explique Chris Kenyon, professeur à l'IMT. "Si c'est le cas, imaginez l'effet de la consommation mondiale de ces doses au cours d'une vie. Cela pourrait contribuer à l'accélération de la résistance que nous observons actuellement", souligne Kenyon.
L'étude critique les normes actuelles d'utilisation des antibiotiques dans la production alimentaire et appelle à une réévaluation afin de prévenir l'augmentation des souches bactériennes impossibles à traiter.
Références
Laumen, J.G.E., Van Dijck, C., Abdellati, S. et al. Antimicrobial susceptibility of commensal Neisseria in a general population and men who have sex with men in Belgium. Sci Rep 12, 9 (2022).
Gestels Z, Baranchyk Y, Van den Bossche D, Laumen J, Abdellati S, Britto Xavier B, Manoharan-Basil SS, Kenyon C. Could traces of fluoroquinolones in food induce ciprofloxacin resistance in Escherichia coli and Klebsiella pneumoniae? An in vivo study in Galleria mellonella with important implications for maximum residue limits in food. Microbiology Spectrum. 2024 Apr 30:e03595-23.
Baranchyk Yuliia, Zina Gestels, Dorien Van Den Bossche, et al. Effect of erythromycin residuals in food on the development of resistance in Streptococcus pneumoniae: an in vivo study in Galleria mellonella. PeerJ. 2024.
Thèmes de recherche

La résistance aux antimicrobiens
Plus d'infoFaites passer le mot ! Partagez cette nouvelle sur